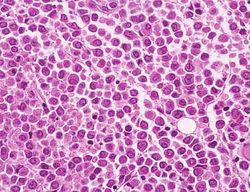

Anno 2011 Associazione donatori midollo osseo di Piacenza - Progetto di ricerca immunogenetica
Progetto annuale
Lo stanziamento è relativo al finanziamento di un progetto di ricerca immunogenetica dellAdmo presso il centro trasfusionale. In particolare, il contributo della Fondazione di Piacenza e Vigevano alla ricerca si concretizza con il pagamento di una borsa di studio riservato ad una biologa, che ha frequentato il laboratorio acquisendo esperienza nelle tecniche di tipizzazione al citofluorimetro e nel congelamento delle cellule staminali. Lo stanziamento è relativo al finanziamento di un progetto di ricerca immunogenetica dellAdmo presso il centro trasfusionale. In particolare, il contributo della Fondazione di Piacenza e Vigevano alla ricerca si concretizza con il pagamento di una borsa di studio riservato ad una biologa, che ha frequentato il laboratorio acquisendo esperienza nelle tecniche di tipizzazione al citofluorimetro e nel congelamento delle cellule staminali.
Il laboratorio di Immunogenetica HLA, parte integrante del servizio di Immunoematologia e Medicina trasfusionale dellospedale di Piacenza, dal 2009 è accreditato - unico in regione insieme al centro di Immunogenetica di Bologna - dallEuropean Federation for Immunogenetics (Efi). Svolge attività per definire le caratteristiche genetiche richieste per i donatori di midollo osseo che vogliono iscriversi al registro IBMDR (Italian Bone Marrow Donors Registry) di cui il laboratorio fa parte come Centro Donatori e Centro Prelievi di midollo osseo.
Inoltre, studia le caratteristiche genetiche dei pazienti oncoematologici da avviare al trapianto di midollo allogenico (da donatore a ricevente) e la suscettibilità genetica dei pazienti con sospette patologie autoimmuni.
Altre ricerche riguardano: lutilizzo di farmaci in base allassetto genetico dei pazienti in particolari regimi terapeutici (farmocogenetica e terapie personalizzate); la genetica dei gruppi sanguigni; le mutazioni genetiche per la diagnosi dellemocromatosi ereditaria.
Il laboratorio conta la presenza di due biologi specializzati in ruolo, e laiuto (condiviso con il laboratorio di citofluorimetria e cellule staminali) di una biologa specializzanda in Patologia clinica. La borsa di studio che sostiene lattività della specializzanda è stata istituita ad aprile 2011 dallAdmo-Associazione donatori di midollo osseo, grazie a fondi in maggior entità erogati dalla Fondazione di Piacenza e Vigevano.
Nel 2011 la Fondazione di Piacenza e Vigevano ha contribuito al progetto con un sostegno di 10.000,00 .
|



